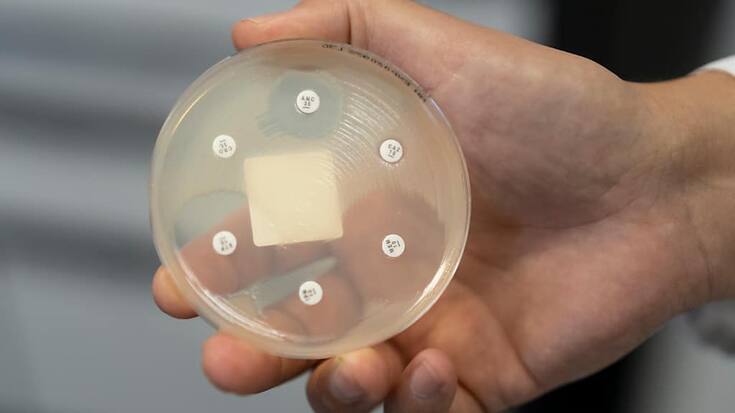
20221110090723831

Bonjour,
Les efforts contre l'antibiorésistance portent leurs fruits (étude)
La consommation d'antibiotiques en médecine humaine et vétérinaire en Suisse a nettement reculé ces deux dernières années. La situation en matière de résistance à ces médicaments tend à s'améliorer, mais il reste des efforts à faire, selon un bilan dressé jeudi.
ats
Publicité
Le rapport suisse 2022 sur la résistance aux antibiotiques, présenté devant les médias à Berne, révèle un état des lieux plutôt encourageant, sept ans après le lancement de la stratégie "antibiorésistance" (StAR) en réaction à la hausse continue de la résistance à ces médicaments constatée à l'époque chez les êtres humains et les animaux.
Depuis 2015, "bien des choses ont changé", lit-on dans le rapport présenté par les Offices fédéraux de la santé publique (OFSP), de la sécurité alimentaire et des affaires vétérinaires (OSAV), de l’agriculture (OFAG) et de l’environnement (OFEV). Les experts citent notamment les recommandations permettant de réduire la propagation des germes (résistants) dans les hôpitaux, les cabinets vétérinaires et les élevages.
Contrairement aux craintes initiales, le Covid-19 n'a pas entraîné d'augmentation de la consommation d'antibiotiques. L'hygiène accrue (lavage des mains, port du masque) et la réduction des contacts "ont même eu des effets positifs, notamment en ce qui concerne l’antibiorésistance", relèvent les experts.
La Suisse "bonne élève"
Pendant la pandémie, la consommation globale d'antibiotiques (en ambulatoire et à l'hôpital) en Suisse a nettement diminué: -19% entre 2019 et 2021, pour descendre à 8,6 doses définies journalières par 1000 habitants et par jour (DID). Environ 85% de cette consommation est faite en ambulatoire.
En comparaison européenne, la Suisse continue à faire partie des pays recourant le moins aux antibiotiques. Sa consommation est près de moitié inférieure à celle de la moyenne des pays de l'UE, qui se situe à 16,4 DID (état 2020).
La Suisse enregistre un recul particulièrement important, de près de 40% sur dix ans, de la consommation des antibiotiques classés "watch" (à utiliser avec précaution). Elle est passée de 5,4 DID en 2012 à 3,1 en 2021. Ces antibiotiques représentent aujourd'hui en Suisse 36% des prescriptions, soit moins que la valeur de référence prescrite par l'OMS (40%).
300 décès par an
A noter qu'il existe des différences régionales. Les Romands et les Tessinois ont davantage recours aux antibiotiques que les Alémaniques. Les affections les plus couramment traitées par ces médicaments sont les infections urinaires (40% de l'ensemble des antibiotiques administrés).
La résistance aux antibiotiques cause quelque 300 décès par an en Suisse. Proportionnellement à sa population, le pays est moins touché par ce problème que la France ou l’Italie, mais plus que les Pays-Bas et les pays scandinaves.
D'une façon générale, l'antibiorésistance semble se stabiliser ces dernières années en Suisse. Mais les tendances varient selon le type de bactéries. Pour le staphylocoque doré, le taux de résistance a été réduit de moitié ces quinze dernières années.
Publicité
Dans le secteur vétérinaire aussi, la tendance est nettement à la baisse. Depuis 2012, le recours aux antibiotiques y a diminué de plus de 50 %. Les boeufs sont, de très loin, les plus concernés par l'administration de ces produits (près de 80% du total).
Les stations d'épuration sont équipées depuis 2016 de dispositifs permettant d'éliminer les micropolluants comme les antibiotiques. A l'horizon 2040, 70% des eaux usées du pays devraient bénéficier de ce type de traitements.
Au rayon alimentaire, concernant la viande fraîche suisse, les spécialistes observent aussi une nouvelle diminution des contaminations par des bactéries résistantes.
Problème mondial
Mais attention, préviennent les experts. De nouvelles méthodes de séquençage de l'ADN permettent de constater "une forte colonisation d'agents pathogènes résistants chez les voyageurs de retour en Suisse". Elles ont également montré que les patients sortant d’hospitalisation transmettaient à leurs proches des bactéries résistantes. En outre, dans les cliniques vétérinaires, ces bactéries se transmettent entre les équipes et les animaux qui y sont traités. Des mesures ciblées s'imposent.
Les comparaisons internationales du Global Health Index attribuent à la Suisse les meilleures notes pour ses efforts contre l'antibiorésistance. Mais le problème garde toute son acuité au plan mondial en particulier: ce fléau fait chaque année 1,3 million de morts, davantage que le paludisme ou le sida.
Publicité
Publicité